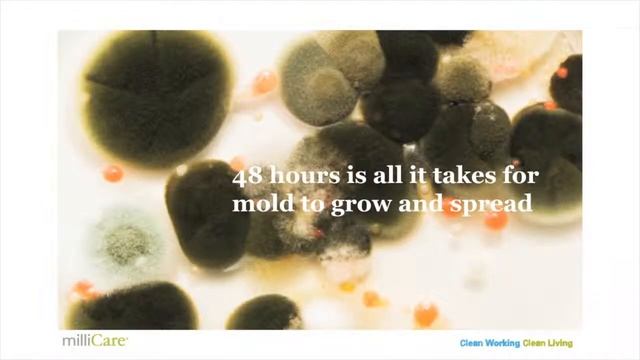
milliCare's Dry Centered Method = No Mold смотреть онлайн

Автор: Физические эксперименты для астрофизиков Страница 8

Tera Online Beta - Mystic Spotlight

09062019 gudauri paragliding with SkyAtlantida Team полет гудаури بالمظلات، جورجيا بالمظلات SkyAtl

01 Wisin & Yandel feat 50 Cent Mujeres In The Club

Нашид Абу Али-Остатки былой славы Abu Ali nasheed Baqaya Al Majd

how to be THAT girl

Workout: Triplet Ladder
![Girl From Nowhere [3] Reaction Preview смотреть онлайн](https://pic.rutubelist.ru/video/2025-01-24/90/2e/902ea5a56a4f80456a86e0a876727b41.jpg?size=m)
Girl From Nowhere [3] Reaction Preview

Олег Воробьев "Я возвращаю себе страну"

boywithuke - toxic (slowed + reverb)

Google ads adwords campaign gig create on fiverr ! Google ads gig ! learning and teaching bd! googl

Ich Will Ja Nichts Als Deine Liebe

Человеческий ГЛАЗ и ЗРЕНИЕ | Face ID | Что значит быть ЧЕРНОВИКОМ

Klasky Csupo Meets Super Duper Muper Ultra Tera Giga Mega Super Very Lots of Csupos (1)

Пастеризатор вина 1000 л/год WP-1.0P

exercice sur pascal

MK feat. Milly Pye - Bring Me To Life ( Dantiez Saunderson Remix )

Отделка лоджии

Я побывала на проекте "я стесняюсь своего тела"

Carnival Onboard Fun (and Food)

Перепайка диодов в диодной ленте

18- DECIMA OCTAVA CLASE a los Niños - La Gracia Santificante
milliCare's Dry Centered Method = No Mold

у меня дома радиация!!!

ALMANYA'DAN DUL AYLIĞI ALANLARIN BİLMESİ GEREKENLER...
За каждым успешным каналом стоит личность, идея и сотни часов кропотливого труда. Если вы здесь, значит, автор «Физические эксперименты для астрофизиков» уже сумел зацепить ваше внимание своим уникальным стилем или подачей. А мы на RUVIDEO позаботились о том, чтобы вы могли изучить весь архив его работ в максимально комфортных условиях — без лишней суеты и преград.
Почему за работами канала «Физические эксперименты для астрофизиков» так интересно наблюдать? Всё просто: это честный контент, который находит отклик в сердцах зрителей. На нашем ресурсе вы можете смотреть онлайн все видео любимого автора бесплатно и в хорошем качестве. Нам важно, чтобы вы видели каждую деталь и слышали каждый нюанс, поэтому мы используем только стабильные плееры из открытых источников Rutube.
Следите за новинками канала, пересматривайте старые шедевры и открывайте для себя новые грани творчества «Физические эксперименты для астрофизиков». Мы постоянно обновляем ленту, чтобы у вас под рукой всегда были самые свежие выпуски. Никаких сложных регистраций — только вы и творчество, которое вдохновляет. Приятного вам путешествия по миру авторского контента на RUVIDEO!
Видео взято из открытых источников Rutube. Если вы правообладатель, обратитесь к первоисточнику.